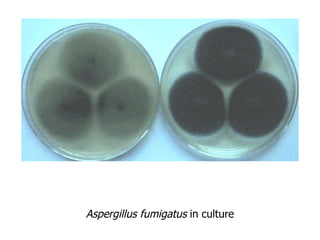
Aspergillus fumigatus  in culture
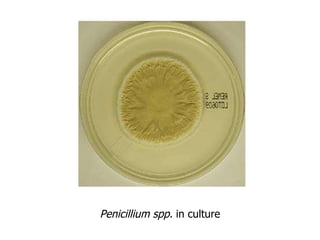
Penicillium spp.  in culture

The document presented by Wane A. Baker discusses indoor environmental quality (IEQ) and its impact on health, focusing on indoor air quality definitions, microbiological contaminants, thermal comfort, and adequate ventilation standards. It covers the various health effects related to poor IEQ such as sick building syndrome and building-related illnesses, alongside guidelines for mold investigations and remediation. Additionally, it outlines historical ventilation requirements and contemporary standards for ensuring acceptable indoor air quality.

![Indoor Environmental Quality The Basics – and More Historical guidelines Past building codes Current requirements Proposed addenda to ASHRAE Std. 62-1999 ADEQUATE VENTILATION Outdoor air ventilation [cfm/occupant or cfm/sq ft] vs. total airflow [air changes per hour]](https://image.slidesharecdn.com/thebasicsandmoresept2002michaelsengineering-1302985251161-phpapp02/85/Indoor-Air-Quality-The-Basics-And-More-44-320.jpg)


![The history of building codes in the State of Wisconsin has left a legacy of schools, offices and commercial spaces ventilated at 1/3 to 1/2 of the current minimum rate recommended by ASHRAE: Wisconsin Administrative Code, Comm. 64.05(2)(a) [Table 64.05]: changed from 5 cfm/occupant to 7-1/2 cfm/occupant in April 1996, but was “stayed” until April 1997. Indoor Environmental Quality ADEQUATE VENTILATION (cont’) Building Codes](https://image.slidesharecdn.com/thebasicsandmoresept2002michaelsengineering-1302985251161-phpapp02/85/Indoor-Air-Quality-The-Basics-And-More-47-320.jpg)










![Indoor Environmental Quality The Basics – and More Definition: all types of airborne solid and liquid particles; sizes range from 0.005 – 100 microns [ m] Comparisons diameter human hair: 60-70 microns smallest visible: 20-30 microns Particles >30 microns unlikely to enter nasal passages Inhalable (thoracic) particles: <10 microns (PM 10 ) Fine (respirable) particles: <2.5 microns (PM 2.5 ) IH definition: < 4 microns (median cut-point) Ultrafine particles (UFP): <0.1 micron PARTICULATE MATTER](https://image.slidesharecdn.com/thebasicsandmoresept2002michaelsengineering-1302985251161-phpapp02/85/Indoor-Air-Quality-The-Basics-And-More-58-320.jpg)


![Thank you! Wane A. Baker, P.E., CIH Michaels Engineering Inc. La Crosse, WI 608/785-1900 Email: [email_address] Website: www.michaelsengineering.com Indoor Environmental Quality The Basics – and More QUESTIONS??](https://image.slidesharecdn.com/thebasicsandmoresept2002michaelsengineering-1302985251161-phpapp02/85/Indoor-Air-Quality-The-Basics-And-More-61-320.jpg)